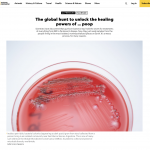

Making poop look good – my macro photography in National Geographic
To illustrate a story on the role of bacteria from human guts as a source of treatments for a variety of illnesses, National Geographic asked me to visit researchers and document their samples. Click on the image below to read the story online!
New photo book „Magie der Meeresschildkröten“

Immerse yourself in the fascinating world of sea turtles with my new photo book „Magie der Meeresschildkröten“ published by Delius Klasing! You can get to know the different species, follow them on their underwater journeys and learn more about their nesting habits as well as sea turtle conservation and research. The texts were written by […]
Image of Distinction at the 2025 Nikon Photomicrography Competition

Photographing small animals is close to my heart – and for the third time the Nikon Photomicrography Competition has recognised my work. This year, a close-up of a tiny blue sea dragon was selected as an “Image of Distinction”. The photo shows parts of the feathered arms that the tiny sea slug Glaucus atlanticus uses to […]
Exhibition “Expedition to the World’s Oceans” at Bundeskunsthalle Bonn

An exhibition that takes you on an expedition – this is the new show at Bundeskunsthalle in Bonn. Precious paintings, photos, videos, models and original objects from nature, science and technology inspire you to reflect on the various relationships between humankind and the ocean. The exhibition concentrates on three main subjects: The deep sea with […]
Finalist at Ocean Photographer of the Year 2025

My portrait of a spawning brittle star at the Caribbean island of Bonaire made it into the finals of the “Conservation (Hope)” category of the Oceanographic Magazine’s Ocean Photographer of the Year 2025 competition. Rearing up on the tips of its arms on top of a coral, this female releases its eggs, a few nights […]
Exhibition “Wunder der Tiefsee” at Museum Eckernförde

My photos of deep-sea plankton, fish and jellyfish, molluscs and crustaceans are presented at Museum Eckernförde until early January 2025. Come and get to know these amazing creatures who have adapted to a life in the darkness, at high pressure and low temperatures! Some of these animals are only a few milimetres in size and […]
GEO magazine: “Die Rumtreiber” about neuston

Have you ever heard about neuston, animals that live at the ocean surface? I have been looking out for these fascinating sea slugs, jellies, crustaceans, cephalopods and even an insect on several of my expeditions to the Atlantic and Mediterranean Sea. The current issue of GEO magazine presents some of my images.
Exhibition “Planet Ocean” at Gasometer Oberhausen
The ocean in all its fascinating forms and colours is celebrated in the exhibition “Planet Ocean” at Gasometer Oberhausen. I am proud to present my work in the section about the deep sea – and to be featured at this prestigious location for the fifth time. Large-format photos and videos as well as the sound […]
Calendar “Tiefseewesen” 2024

Spend your year 2024 with octopuses, plankton, fish and many other fascinating creatures of the deep sea! My “Tiefseewesen” calendar 2024 shows the variety of life far below the ocean’s surface. The collection of high-quality images was awarded with the “Kalenderpreis 2023 des Deutschen Buchhandels”.
European Wildlife Photographer of the Year 2023

I have the honour of receiving awards for two of my images in the “European Wildlife Photographer of the Year” 2023 competition. It feels incredible to be the runner up for the “Other Animals” category and to have another image “highly commended” in the “Underwater World” category. Congratulations to all the winners! Further information and […]
Wildlife Photographer of the Year 2023

I am excited to share that my image of a busy mason bee is “Highly Commended” in the “Wildlife Photographer of the Year” 2023 competition. This is the fifth time that my work is recognised in the competition. Congratulations to all other awarded photographers! Please visit the Natural History Museum website for more details and […]
GEO magazine: “Wild auf rot” about poppy bees

So great to see that my photo story of the poppy bee is featured in the latest issue of the GEO magazine. Poppy bees have become very rare because they depend on poppy and corn flowers to build their nests. I was lucky enough to observe and photograph them in Frankonia, Germany.
stern magazine

The current issue of ‘stern‘ is featuring my pictures of deep-sea animals I took during a 74-day research cruise in the Atlantic. I joined the team on board the RV Sonne to photograph the diversity of creatures found in the deep sea in the Benguela upwelling region off the coast of South Africa and Namibia. […]
Calendar “Tiefseewesen 2023”

Treat yourself to portraits of iconic creatures from the deep sea with my large-format “Tiefseewesen” calendar 2023. It includes twelve of my best images of plankton, jellyfish, octopuses and other animals photographed during marine research expeditions and black-water dives.
BBC Wildlife magazine

Living Lightbulbs: BBC Wildlife presents some of my images of bioluminescent animals in their March issue. Have a look and get fascinated by squid, jellyfish, sea anemones and tiny crustaceans, fireflies and glow worms that produce light in their bodies to attract partners and prey, scare off predators or to communicate with their peers! #bioluminescence […]
New photo book „Tiefseewesen“

I am excited to announce that my new photo book „Tiefseewesen“ is available now! My portraits of deep-sea animals and Maike Nicolai’s texts take you to the most fascinating ecosystem of our planet. The foreword is written by deep-sea biologist Dr. Diva Amon from Natural History Museum in London. Because I am currently out at […]












